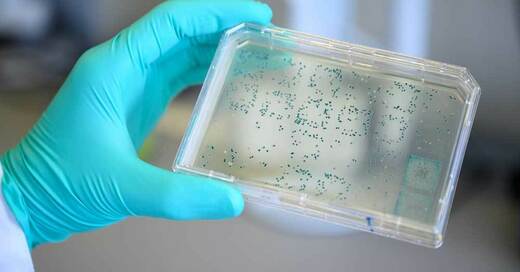

Tag Archiv: Sasbach
 08. März 2024
Ein weiterer Wolf ist im Schwarzwald sesshaft geworden
Das Tier ist seit Sommer im Ortenaukreis unterwegs (…)
08. März 2024
Ein weiterer Wolf ist im Schwarzwald sesshaft geworden
Das Tier ist seit Sommer im Ortenaukreis unterwegs (…)
 04. März 2024
Entscheidung bei drei Bürgermeisterwahlen in Südbaden
Weil am Rhein wählt erstmals Frau an die Stadtspitze (…)
04. März 2024
Entscheidung bei drei Bürgermeisterwahlen in Südbaden
Weil am Rhein wählt erstmals Frau an die Stadtspitze (…)
 07. Juni 2023
In Südbaden beginnt die Rebblüte – Countdown bis zur Weinlese
In 90 bis 100 Tagen beginnt die Lese - Hoffnung auf sonnige Witterung (…)
07. Juni 2023
In Südbaden beginnt die Rebblüte – Countdown bis zur Weinlese
In 90 bis 100 Tagen beginnt die Lese - Hoffnung auf sonnige Witterung (…)
 25. August 2022
Energiewerk Ortenau stellt zum Jahresende den Betrieb ein
Betroffen sind rund 5.800 Strom- und Gaskunden in der Ortenau (…)
25. August 2022
Energiewerk Ortenau stellt zum Jahresende den Betrieb ein
Betroffen sind rund 5.800 Strom- und Gaskunden in der Ortenau (…)
 18. Oktober 2021
Mehrere Gemeinden im Landkreis Emmendingen ohne Strom
Der Netzbetreiber arbeitet wohl an der Behebung, ab wann wieder Strom fließt ist noch unklar (…)
18. Oktober 2021
Mehrere Gemeinden im Landkreis Emmendingen ohne Strom
Der Netzbetreiber arbeitet wohl an der Behebung, ab wann wieder Strom fließt ist noch unklar (…)
 17. September 2021
Gefährliches Hindernis über Fußweg und Spielplatz in Sasbach gespannt
Ein nur schwer sichtbarer Draht hätte nach Ansicht der Ermittler schnell zu schweren Unfällen führen können. (…)
17. September 2021
Gefährliches Hindernis über Fußweg und Spielplatz in Sasbach gespannt
Ein nur schwer sichtbarer Draht hätte nach Ansicht der Ermittler schnell zu schweren Unfällen führen können. (…)
 08. April 2021
Spürhund entdeckt über 30 Kilogramm Drogen bei Zollkontrolle in Sasbach
Der 48-jährige Fahrer war auf dem Heimweg von Belgien über das Elsass nach Deutschland eingereist. (…)
08. April 2021
Spürhund entdeckt über 30 Kilogramm Drogen bei Zollkontrolle in Sasbach
Der 48-jährige Fahrer war auf dem Heimweg von Belgien über das Elsass nach Deutschland eingereist. (…)
 09. Oktober 2020
Nächtliche Sperrung der Rheinbrücke bei Breisach
Die Instandsetzungsarbeiten können nun beginnen (…)
09. Oktober 2020
Nächtliche Sperrung der Rheinbrücke bei Breisach
Die Instandsetzungsarbeiten können nun beginnen (…)
 08. Oktober 2020
Vollsperrung der Kaiserstuhlbahn
Schienenersatzverkehr auf der S5 zwischen Breisach und Sasbach (…)
08. Oktober 2020
Vollsperrung der Kaiserstuhlbahn
Schienenersatzverkehr auf der S5 zwischen Breisach und Sasbach (…)
 28. September 2020
Feuerwerkskörper explodieren und entzünden Haus in Sasbach
Feuerwerk, Wohnhausbrand und Waffen - Großaufgebot der Feuerwehr im Einsatz (…)
28. September 2020
Feuerwerkskörper explodieren und entzünden Haus in Sasbach
Feuerwerk, Wohnhausbrand und Waffen - Großaufgebot der Feuerwehr im Einsatz (…)
06. März 2020
Ärzte weisen weitere Coronavirus-Infektionen in Südbaden nach
Neben einem neuen Fall im Großraum Emmendingen ist nun erstmals auch die Ortenau betroffen. (…)
06. März 2020
Ärzte weisen weitere Coronavirus-Infektionen in Südbaden nach
Neben einem neuen Fall im Großraum Emmendingen ist nun erstmals auch die Ortenau betroffen. (…)
 04. Juni 2019
Verkehrsunfall verursacht Stromausfall in Sasbach
Durch den Aufprall ist ein Fahrzeug gegen einen Stromverteilerkasten gekracht. (…)
04. Juni 2019
Verkehrsunfall verursacht Stromausfall in Sasbach
Durch den Aufprall ist ein Fahrzeug gegen einen Stromverteilerkasten gekracht. (…)